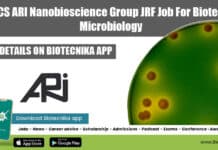
MACS ARI Nanobioscience Group JRF Job For Biotech & Microbiology MACS-ARI Pune JRF

JNCASR Sequencing Project R&D Assistant Recruitment, Applications Invited
JNCASR Sequencing Project R&D Assistant Recruitment, Applications Invited
JNCASR Sequencing Project R&D Assistant Recruitment, Applications Invited. R&D Assistant position at JNCASR. JNCASR Research jobs for...
SNU Technical Officer Job For Life Sciences, Applications Invited
SNU Technical Officer Job For Life Sciences, Applications Invited
SNU Technical Officer Job For Life Sciences, Applications Invited. Shiv Nadar University is hiring MSc candidates...
Post-Doctoral Fellow In Informatics at Tata Medical Center, Kolkata
Post-Doctoral Fellow In Informatics at Tata Medical Center, Kolkata
Post-Doctoral Fellow In Informatics at Tata Medical Center, Kolkata. PhD Bioinformatics/ Biotechnology Post-Doctoral Fellow in Informatics...
Bayer Seed Analyst Job – MSc & PhD Microbiology, Mol Bio Apply Online
Bayer Seed Analyst Job - MSc & PhD Microbiology, Mol Bio Apply Online
Bayer Seed Analyst Job - MSc & PhD Microbiology, Mol Bio Apply...
Mondelēz Chocolate Mass Scientist – Online Application Process
Mondelēz Chocolate Mass Scientist - Online Application Process
Mondelēz Chocolate Mass Scientist - Online Application Process. Mondelez research jobs. Scientist I - Chocolate Mass job...
CSIR-NEERI Microbiology Project Associate Recruitment, Applications Invited
NEERI Microbiology Project Job Opening, Applications Invited
NEERI Microbiology Project Job Opening, Applications Invited. MSc Microbiology project associate job at CSIR-NEERI. CSIR - National Environmental...
Sardar Patel SPRERI Research Fellow Job For Life Sciences, Biotech
SPRERI JRF Job 2022 For MSc & MTech Life Sciences
SPRERI JRF Job 2022 For MSc & MTech Life Sciences. Sardar Patel Renewable Energy Research...
CSIR-IMTECH Project Associate Recruitment – Online Application Process
CSIR IMTECH 2022 Vacancy - Applications Invited Online
CSIR IMTECH 2022 Vacancy - Applications Invited Online. Project Associate Recruitment. Interested and eligible applicants can check...
Mars Wrigley Food Science Lab Technologist Recruitment, Apply Online
Mars Wrigley Food Science Lab Technologist Recruitment, Apply Online
Mars Wrigley Food Science Lab Technologist Recruitment, Apply Online. Food Sciences job openings for Indian nationals...
MACS ARI Nanobioscience Group JRF Job For Biotech & Microbiology
MACS-ARI Pune JRF Job For Biotech & Microbiology
MACS-ARI Pune JRF Job For Biotech & Microbiology. MSc Biotechnology and Microbiology JRF Job. JRF job openings...
MSc Biotech & Microbiology Job With 0 to 3 Years Exp at Springer Nature
Springer Nature Vacancy 2022 - Biotech & Microbiology Apply Online
Springer Nature Vacancy 2022 - Biotech & Microbiology Apply Online. MSc Biotechnology, Microbiology SJr. Editorial...
Biotecnika Times Newsletter 18.05.2022 35+ Govt SSC Recruitment, Govt Dept of Atomic
Biotecnika Times - 35+ Govt SSC Recruitment, Govt Dept of Atomic
35+ Govt SSC Staff Selection Commission Recruitment 2022, Online Application Process
SSC Staff Selection 2022...
Top 10 FREE Bioinformatics Online Tools You Must Know
Free Bioinformatics Tools Online - Top 10 Best Free Bioinformatics Tools
For today's video, we will look at the top 10 bioinformatics tools that all...
35+ Govt SSC Staff Selection Commission Recruitment 2022, Online Application Process
SSC Staff Selection 2022 Jobs, Apply Online
SSC Staff Selection 2022 Jobs, Apply Online. MSc, BTech and BSc candidates apply. Botany, Zoology, Agriculture, Biotechnology, Biochemistry,...
inStem Biological Sciences Project Associate Jobs 2022, Apply Online
inStem Vacancies 2022 - MSc Biological Sciences Apply Online
inStem Vacancies 2022 - MSc Biological Sciences Apply Online. MSc Biological Sciences project associate vacancies. Interested...